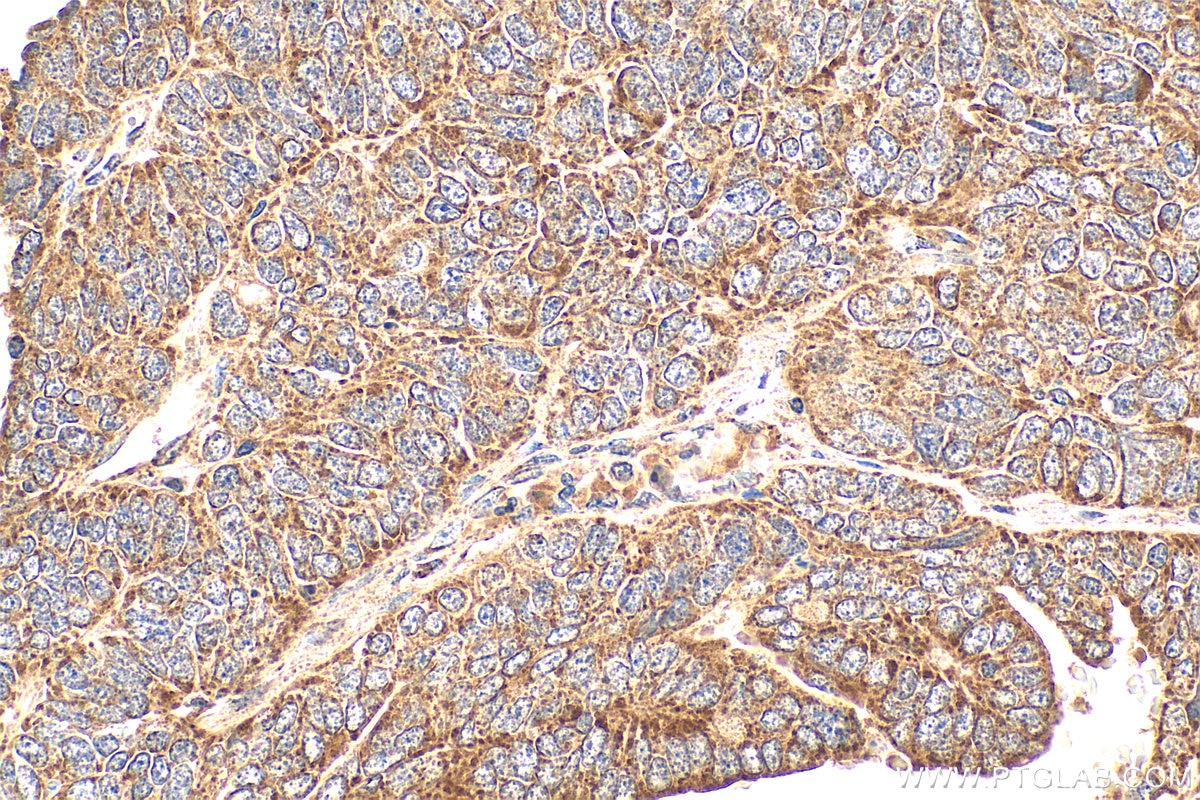
Immunohistochemistry (IHC) staining of human ovary tumor tissue using Osteopontin Polyclonal antibody (22952-1-AP)

Tested Applications
| Positive WB detected in | HEK-293 cells, HepG2 cells, Jurkat cells |
| Positive IHC detected in | human ovary tumor tissue Note: suggested antigen retrieval with TE buffer pH 9.0; (*) Alternatively, antigen retrieval may be performed with citrate buffer pH 6.0 |
| Positive IF/ICC detected in | HepG2 cells, HEK-293 cells |
| Positive FC (Intra) detected in | HepG2 cells |
Recommended dilution
| Application | Dilution |
|---|---|
| Western Blot (WB) | WB : 1:500-1:2000 |
| Immunohistochemistry (IHC) | IHC : 1:50-1:500 |
| Immunofluorescence (IF)/ICC | IF/ICC : 1:200-1:800 |
| Flow Cytometry (FC) (INTRA) | FC (INTRA) : 0.40 ug per 10^6 cells in a 100 µl suspension |
| It is recommended that this reagent should be titrated in each testing system to obtain optimal results. | |
| Sample-dependent, Check data in validation data gallery. | |
Published Applications
| KD/KO | See 10 publications below |
| WB | See 308 publications below |
| IHC | See 112 publications below |
| IF | See 121 publications below |
| ELISA | See 1 publications below |
| CoIP | See 2 publications below |
Product Information
22952-1-AP targets Osteopontin in WB, IHC, IF/ICC, FC (Intra), CoIP, ELISA applications and shows reactivity with human samples.
| Tested Reactivity | human |
| Cited Reactivity | human, pig, rabbit, bovine |
| Host / Isotype | Rabbit / IgG |
| Class | Polyclonal |
| Type | Antibody |
| Immunogen |
CatNo: Ag19216 Product name: Recombinant human OPN, SPP1 protein Source: e coli.-derived, PGEX-4T Tag: GST Domain: 13-300 aa of BC007016 Sequence: ITCAIPVKQADSGSSEEKQLYNKYPDAVATWLNPDPSQKQNLLAPQTLPSKSNESHDHMDDMDDEDDDDHVDSQDSIDSNDSDDVDDTDDSHQSDESHHSDESDELVTDFPTDLPATEVFTPVVPTVDTYDGRGDSVVYGLRSKSKKFRRPDIQYPDATDEDITSHMESEELNGAYKAIPVAQDLNAPSDWDSRGKDSYETSQLDDQSAETHSHKQSRLYKRKANDESNEHSDVIDSQELSKVSREFHSHEFHSHEDMLVVDPKSKEEDKHLKFRISHELDSASSEVN Predict reactive species |
| Full Name | secreted phosphoprotein 1 |
| Calculated Molecular Weight | 314 aa, 35 kDa |
| Observed Molecular Weight | 70 kDa, 44-66 kDa |
| GenBank Accession Number | BC007016 |
| Gene Symbol | Osteopontin |
| Gene ID (NCBI) | 6696 |
| RRID | AB_2783651 |
| Conjugate | Unconjugated |
| Form | Liquid |
| Purification Method | Antigen affinity purification |
| UNIPROT ID | P10451 |
| Storage Buffer | PBS with 0.02% sodium azide and 50% glycerol, pH 7.3. |
| Storage Conditions | Store at -20°C. Stable for one year after shipment. Aliquoting is unnecessary for -20oC storage. 20ul sizes contain 0.1% BSA. |
Background Information
Osteopontin (OPN), also known as SPP1, is a secreted glycophosphoprotein that belongs to the small integrin-binding ligand N-linked glycoprotein (SIBLING) family. Originally isolated from bone, OPN has been found in kidneys, vascular tissues, biological fluids, and various tumor tissues (PMID: 15138464; 16406521). OPN can interact with CD44 and integrins and regulate diverse biological processes. It has a multifaceted role in bone development and remodeling, and is also involved in the inflammatory and immune response, oncogenesis and cancer progression. The very acidic nature of OPN, as well as the presence of variable posttranslational modifications, has led to anomalous migration in SDS-polyacrylamide gels and therefore to reports of different molecular weights for OPN (PMID: 8293561). Depending on the cell and tissue source and/or the SDS-PAGE system, OPN migrates with a molecular weight of 44-80 kDa, as well as at some smaller bands corresponding to peptide fragments (PMID: 8195113; 17890765).
Protocols
| Product Specific Protocols | |
|---|---|
| FC protocol for Osteopontin antibody 22952-1-AP | Download protocol |
| IF protocol for Osteopontin antibody 22952-1-AP | Download protocol |
| IHC protocol for Osteopontin antibody 22952-1-AP | Download protocol |
| WB protocol for Osteopontin antibody 22952-1-AP | Download protocol |
| Standard Protocols | |
|---|---|
| Click here to view our Standard Protocols |
Publications
| Species | Application | Title |
|---|---|---|
Circulation Carbonylation of Runx2 at K176 by 4-Hydroxynonenal Accelerates Vascular Calcification | ||
Adv Mater Realizing Highly Efficient Sonodynamic Bactericidal Capability through the Phonon-Electron Coupling Effect Using Two-Dimensional Catalytic Planar Defects | ||
Cell Stem Cell Decoding the temporal and regional specification of microglia in the developing human brain. | ||
Nat Aging Single-cell and spatial RNA sequencing identify divergent microenvironments and progression signatures in early- versus late-onset prostate cancer | ||
Bioact Mater Urchin-like multiscale structured fluorinated hydroxyapatite as versatile filler for caries restoration dental resin composites | ||
Nat Cell Biol Single-cell reconstruction of the adult human heart during heart failure and recovery reveals the cellular landscape underlying cardiac function. |
Reviews
The reviews below have been submitted by verified Proteintech customers who received an incentive for providing their feedback.
FH Wenhan (Verified Customer) (01-30-2026) | Great! It can used in JESS!
|
FH Apoorva (Verified Customer) (06-04-2025) | The antibody worked well with both tissues and cell. I tested the product with both IHC and IF
|
FH Shinford (Verified Customer) (10-26-2023) | The WB bands exhibit remarkable strength and clarity, with various treatments leading to significant changes in expression.
![]() |
FH Shinford (Verified Customer) (09-24-2023) | This antibody works well in esophageal cancer and lung cancer cell lines, and the detection antibody band is clear. It is recommended to use a diluted concentration of 1:2000.
![]() |
FH Elisa (Verified Customer) (08-16-2023) | Tested on mouse skull sections, with appropriate blocking: give a nice stain of osteopontin, but maybe it can be optimized to be able to use an higher dilution.
|
FH Davide (Verified Customer) (09-20-2022) | The antibody works really well. Fantastic product, and the possibility to try the product with the free sample is something really appreciated. Will surely buy a full vial soon.
![]() |
FH WEI (Verified Customer) (03-08-2022) | Strong specific Bands
|
FH LUNFENG (Verified Customer) (01-27-2020) | VERY GOOD
|
FH Jie (Verified Customer) (01-23-2020) | Works with one specific band and one faint non-specific band. However, can be distinguished by protein size. So works fine in general.
|
FH Jingwen (Verified Customer) (01-17-2020) | This antibody showed the specific band and staining results in both western blot and immunofluorescence staining. I strongly recommend it.
|
FH Barbara (Verified Customer) (09-28-2019) | Fluorescence-based detection of OPN (green) expression in paraffin-embedded human aortic tissue, heat mediated antigen retrival with 10mM citrate buffer (pH 6,0)
![]() |